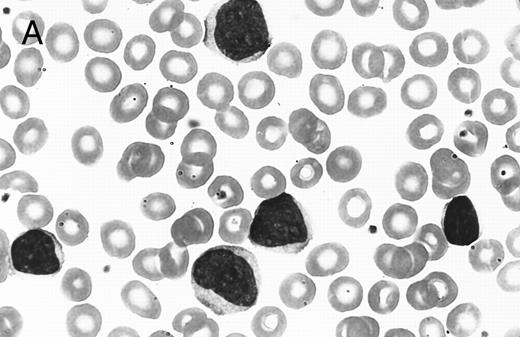
Fig. 5. (A) PB involvement in MCL is characterized by a polymorphous cell population including larger cells with immature nuclei and prominent nucleoli. (B) OS of 80 cases of MCL based on PB involvement at diagnosis. Those cases positive for PB involvement (n = 27) were associated with a significantly shorter survival when compared with those in which PB was not involved or not assessed (n = 53).

Abstract
Mantle cell lymphoma (MCL) is a relatively uncommon yet distinct type of malignant lymphoma whose clinical and pathological characterization has been limited by the small numbers of cases published to date. We studied 80 cases of MCL seen at a single institution over 7 years to determine both clinical and pathological prognostic factors. The patients in this study were predominantly male (70%) and older (mean age, 63 years) and presented with advanced-stage disease (88%). Extranodal involvement was common. Median overall survival (OS) was 43 months. Except for performance status, prognosis was not significantly influenced by clinical prognostic factors. Histologically, MCL architecture was classified as diffuse (78%), nodular (16%), or mantle zone (6%); the OS among these groups was identical. Increased mitotic activity (<20 mitotic figures per 10 high power fields), blastic transformation, and peripheral blood involvement at diagnosis also predicted for a worse outcome, but bone marrow involvement did not. The presence or absence of a translocation t(11; 14) by cytogenetic analysis or a bcl-1 rearrangement by Southern analysis did not significantly predict outcome. In summary, this study of 80 cases of MCL highlights its distinctive clinicopathologic features and shows that increased mitotic activity, blastic morphology, and peripheral blood involvement at diagnosis are prognostically important factors.
MANTLE CELL LYMPHOMA (MCL) is a relatively uncommon type of malignant lymphoma (ML) accounting for approximately 5% of ML in North America and Europe. MCL possesses unique morphological, immunophenotypic, cytogenetic, and molecular genetic features, some of which have been elucidated only recently. Based on immunophenotypic and histochemical data, MCL is a neoplasm composed of cells resembling those residing in follicular mantle zones. In the past, MCL has been referred to by various names including intermediately differentiated lymphocytic lymphoma, centrocytic lymphoma, and mantle zone lymphoma (MZL). Cytogenetic and molecular evidence that emerged in the past decade has made it apparent that intermediately differentiated lymphocytic lymphoma, centrocytic lymphoma, and MZL denote a common entity, now referred to as MCL.1 2
Morphologically, MCL can be recognized as a distinct type of ML by its monotonous, diffuse, and/or nodular proliferation of small- to medium-sized cells with slightly irregular nuclei, inconspicuous nucleoli, and absence of both large transformed (noncleaved) cells and proliferation centers. Immunophenotypically, MCL coexpresses pan-B–cell antigens and CD5, a pan-T–cell antigen. A recurring cytogenetic abnormality, t(11; 14), occurs in MCL, resulting in rearrangement of the bcl-1 gene locus and overexpression of the cyclin D1 (CCND1/PRAD1) gene.3 This genetic event is thought to have an important role in the pathogenesis of MCL, because overexpression of cyclin D1 protein is thought to lead to deregulation of the normal cell cycle, particularly at the G1- S-phase transition. Despite refinements in the diagnostic criteria, clinical classification of MCL into existing schemes has been problematic. In the past, most cases of MCL were classified in the Working Formulation as diffuse small cleaved-cell lymphoma, with a minority classified as small lymphocytic, follicular small cleaved-cell, or lymphoblastic lymphoma. These difficulties in classification, as well as the lack of large numbers of cases of MCL for study, have hindered the understanding of its clinical behavior.
Clinically, MCL is considered by most investigators as an ML of intermediate grade, with a median overall survival (OS) of 2 to 5 years.4-12 Some studies suggest that specific morphological subsets of MCL, particularly those with a mantle zone (MZ) pattern, behave in a more indolent manner.13-16 Others have suggested that blastic cell morphology,4-6,13,14 peripheral blood (PB) involvement,8,14,15,17,18 and increased mitotic activity8,11 14 connote a poor prognosis, although the numbers of cases in each study were small. The objective of this study was to examine these and other relevant clinicopathologic variables in a population-based cohort of patients with MCL, diagnosed and treated at the British Columbia Cancer Agency (BCCA). Its aim was not to uncover novel diagnostic features of MCL, but to illustrate the clinical and pathological findings of MCL in British Columbia and to provide further insight into the factors that may have prognostic significance in this disease.
MATERIALS AND METHODS
Patients
Eighty cases diagnosed as MCL between 1988 and 1995 were obtained from the pathology files of the BCCA, the main cancer referral center for the province of British Columbia, which has a population of approximately 3.6 million people. All cases were reviewed by two pathologists to ensure that each case had an adequate tissue biopsy specimen procured before the initiation of treatment and that the biopsy material met the accepted morphological criteria for MCL.1,2 19 Examination of the biopsy material was undertaken without knowledge of any individual patient's outcome. Cases in which treatment was initiated based solely on bone marrow (BM) and/or PB findings were excluded (n = 29) . Detailed clinical information including stage, treatment, and follow-up was available for each of these 80 cases.
Morphology
Tissue biopsy specimens were fixed in buffered formalin or B5 fixative, routinely processed, sectioned at 3 μm, and stained with hematoxylin and eosin. BM biopsy specimens were fixed in B5, decalcified with 10% nitric acid, processed, and sectioned in the usual manner. BM and PB smears were stained with a Wright-Giemsa stain. Immunoperoxidase staining was performed according to well-established protocols.
Immunophenotyping
For immunophenotyping, cell suspensions of tissue and mononuclear cell suspensions of PB and BM specimens were prepared according to well-established methods. A direct antibody-labeling technique was employed using mouse monoclonal antibodies CD2, CD3, CD4, CD5, CD7, CD8, CD10, CD11c, CD14, CD19, CD20, CD23, and CD45 (Becton Dickinson, San Jose, CA); goat polyclonal anti-κ and anti-λ (Tago Inc, Burlingame, CA); and FMC-7 (Silenus Laboratories) labeled with either phycoerythrin or fluorescein isothiocyanate. Specimens were analyzed on the Coulter Epics Profile II flow cytometer (Coulter, Hialeah, FL).
Genetic Analysis
Cytogenetic analyses were performed according to established protocols. Southern analysis (SA) to detect bcl-1 gene rearrangements was performed in a manner similar to previously described methods.20 In summary, high molecular weight DNA was extracted from fresh or frozen material, digested with EcoRI, BamHI, and HindIII restriction endonucleases, electrophoresed on 0.7% agarose gels, and transferred onto nylon filters. A 2.1-kb Sst I fragment representing the major translocation cluster on chromosome 11q13 was used as the probe (courtesy of Dr A. Bakhshi, Bethesda, MD).
Statistics
OS time was defined as the time from diagnosis to the time of death from any cause. Patients still alive were censored at the last known date of contact. Actuarial survival times were estimated by the Kaplan-Meier method.21 Differences in survival between patient groups were analyzed univariately by the log-rank test.22
RESULTS
Clinical Features
MCL comprised approximately 4% of ML cases observed at the BCCA during the 7-year study period. The clinical characteristics of the 80 patients are summarized in Table 1. The median age at presentation was 65 years, with a mean age of 63 years (range, 39 to 86 years). The majority of patients were male, with a male-to-female ratio of 2.3:1. Most patients (88%) presented with advanced-stage disease (IIB bulky, III, or IV). Bulk disease was defined as lymph node masses greater than 10 cm. Extranodal involvement at presentation occurred in 76% of cases; the most common sites were BM (63%), PB (34%), gastrointestinal tract (10%), Waldeyer's ring (10%), and liver (8%). In 25% of cases, extranodal localization of disease was the primary presentation. Multiple lymphomatous polyposis, defined as two or more sites of gastrointestinal mucosal involvement, was found in 5 patients either at presentation or during the course of their disease. Coincident breast cancer was present in 2 patients. The median follow-up period for the entire group was 39 months (range, 1 to 101 months).
Treatment was heterogeneous because of variation in age, stage, symptomatic state, and era of treatment. In general, patients with limited stage disease (IA, IIA nonbulky) received irradiation with or without adjuvant chemotherapy. Patients with advanced-stage disease received chemotherapy based on the clinical behavior of the disease. Those with indolent progression received single-agent chemotherapy, and those with more aggressive disease were treated with multiagent protocols including cyclophosphamide, doxorubicin, and additional agents. A cohort of 16 patients under the age of 60 was treated aggressively with the chemotherapeutic regimen BP-VACOP (bleomycin, cisplatin, etoposide, doxorubicin, cyclophosphamide, vincristine, prednisone) in combination with involved-region radiotherapy (IRRT).23
OS for the whole group of 80 patients is graphically shown in Fig 1, with a median OS of 43 months. Comparisons of OS between clinically relevant patient subsets were performed. Survival was significantly influenced by performance status (PS), in that those patients with PS of greater than 1 (n = 12) had a significantly shorter OS than did those with PS of ≤1 (n = 45; OS, 14 v 45 months; P < .01). Age (≤60 v >60 years), stage (limited versus advanced), serum lactate dehydrogenase (LDH; normal versus elevated), and number of extranodal sites of involvement (≤1 v >1 site) did not significantly predict for patient outcome, but each of these clinical variables did show a trend toward shorter survival in the presence of the respective adverse factor. A calculated International Prognostic Index (IPI) score,24 available for 44 patients, did not significantly predict for patient outcome. Survival differences between clinically relevant treatment groups was limited by small numbers; however, in the group of patients under the age of 60, the BP-VACOP/IRRT group (n = 16) did not have significantly different survival from that of the remainder (n = 13).
Histological Findings
Lymph node biopsy specimens were obtained from 60 patients at presentation, whereas biopsy specimens were obtained from extranodal sites in the remaining 20. All biopsy material fulfilled the diagnostic criteria for MCL.1 19 At low power, lymph nodes were completely effaced by small- to medium-sized lymphocytes in a diffuse and/or nodular pattern. Extranodal tissue, depending on the site, showed either sheets or nodules of small/medium-sized lymphocytes replacing normal structures or invading stromal tissue. No proliferation centers were observed in any case. Occasional compressed germinal centers lacking a normal MZ (naked germinal centers) were observed in a minority of cases with diffuse architecture and were not taken as evidence of a true MZ pattern. At low power, a characteristic mottled pattern was observed, imparted by scattered, large epithelioid histiocytes with pale eosinophilic cytoplasm and no tingible bodies (Fig 2A). In 1 case, the histiocytic component was florid, forming nodules and small sheets. Tingible body macrophages were observed in only a minority of cases; in the 6 cases in which they were numerous (at least one in every high power field [hpf ]), there was evidence of increased cellular proliferation, in particular, increased numbers of mitoses and lymphoblast-like cells. Perivascular hyaline sclerosis was also a feature common to the majority of involved lymph nodes.
Composite photograph showing the three low-power architectural patterns observed in MCL and their prognostic significance: (A) Diffuse pattern; (B) nodular pattern; and (C) MZ pattern. (D) OS of 80 patients based on the predominant architectural pattern observed at diagnosis. No significant differences in OS were shown.
Composite photograph showing the three low-power architectural patterns observed in MCL and their prognostic significance: (A) Diffuse pattern; (B) nodular pattern; and (C) MZ pattern. (D) OS of 80 patients based on the predominant architectural pattern observed at diagnosis. No significant differences in OS were shown.
Cytologically, MCL nuclei were round to ovoid, slightly irregular with inconspicuous nucleoli and slightly clumped chromatin (Fig 3A). Cytoplasm was scant. Larger cells with medium-sized nuclei, fine chromatin, inconspicuous nucleoli, and scant cytoplasm were present in most cases to varying degrees. These cells resembled lymphoblasts rather than large noncleaved cells, prolymphocytes, or paraimmunoblasts. In some cases, lymphoblast-like cells were present in significantly increased numbers (Figs 3B and C), implying cytologic transformation (discussed below). Mitoses were easily found in the majority of cases, the prognostic significance of which is discussed below.
Composite photograph showing the cytologic features of MCL. (A) Typical cytology of MCL characterized by cells with small, slightly irregular nuclei, inconspicuous nucleoli, and minimal cytoplasm. Note the frequent epithelioid histiocytes (arrows). (B) MCL with prominent features of transformation, but not clearly blastic. Increased numbers of larger cells with fine chromatin and inconspicuous nucleoli are shown (arrows). (C) Blastic MCL. Note the cytologic resemblance to lymphoblastic lymphoma. (D) OS of 80 patients with MCL based on the presence of blastic features. The 5 cases designated as blastic MCL were associated with a significantly shorter survival when compared with that of all others (n = 75) including those with features of transformation as shown in (B).
Composite photograph showing the cytologic features of MCL. (A) Typical cytology of MCL characterized by cells with small, slightly irregular nuclei, inconspicuous nucleoli, and minimal cytoplasm. Note the frequent epithelioid histiocytes (arrows). (B) MCL with prominent features of transformation, but not clearly blastic. Increased numbers of larger cells with fine chromatin and inconspicuous nucleoli are shown (arrows). (C) Blastic MCL. Note the cytologic resemblance to lymphoblastic lymphoma. (D) OS of 80 patients with MCL based on the presence of blastic features. The 5 cases designated as blastic MCL were associated with a significantly shorter survival when compared with that of all others (n = 75) including those with features of transformation as shown in (B).
Patterns of pretreatment biopsy architecture, mitotic activity, and features of cytologic transformation were analyzed to determine their prognostic significance in terms of overall patient survival. The criteria used for defining these histological parameters are discussed below, and the results of survival analysis are shown in Figs 2D, 3D, and 4 and are summarized in Table 2.
OS of 80 patients with MCL bases on MS (mitoses/10 random hpf ). An MS of greater than 20 was associated with a significantly shorter survival.
OS of 80 patients with MCL bases on MS (mitoses/10 random hpf ). An MS of greater than 20 was associated with a significantly shorter survival.
Architecture.The architecture of both nodal and extranodal tissue was classified as diffuse, nodular, or MZ according to the predominant pattern observed with the low power (2×) objective and shown in Fig 2. Cases with clear, well-defined nodularity and lacking a significant MZ pattern (n = 13) were classified as “nodular,” similar to those of other investigators.6 Cases with diffuse architecture lacked any nodularity, although scattered, compressed germinal centers were occasionally observed. When a mixture of patterns was encountered, architecture was arbitrarily assigned based on which pattern occupied greater than 50% of the cross-sectional area of all sections available for review. In 5 cases, architecture was difficult to assign for two main reasons, biopsy size and extranodal origin. The 5 biopsy specimens, obtained from colonic, conjunctival, gastric, hepatic, or pleural sites, morphologically fit the criteria of MCL and had ancillary studies providing confirmation. Because none of these 5 biopsy specimens showed any evidence of nodularity, all were arbitrarily assigned to the diffuse category.
Between these architectural subtypes, no statistically significant differences in OS were observed (Fig 2D), nor were any significant differences in OS observed after exclusion of the 20 extranodal cases. Also, no survival differences were observed when the nodular and MZ cases were combined and compared with the cases with a diffuse architecture.
Mitotic activity.A mitotic score (MS) was calculated for each case by counting mitotic figures in 10 hpf (40× objective, 10× ocular) selected at random within a representative tissue section. In virtually all 80 cases, it was found that mitoses were uniformly distributed. This was confirmed by counting mitoses in an additional 10 or 20 hpf in approximately 30% of cases, with special attention to those with low mitotic activity (MS ≤ 5). Overall, the mean MS was 16, with a median of 10 and a range of 0 to 87. In 22 cases the MS was low (≤5), and, of note, 14 of these represented biopsy specimens from extranodal sites. Fewer cases were present at the other extreme, with only 8 cases having an MS greater than 40. On average, the mean MS was higher in cases with diffuse histology (MS = 18) than in those with nodular (MS = 11) and MZ (MS = 7) patterns. A statistically significant difference in OS was observed between those cases with an MS ≤20 and MS greater than 20 (Fig 4). The analysis was repeated with other MS cutoff levels (5, 10, and 15), but 20 was found to be the most discriminant (data not shown). When the 20 extranodal cases were excluded from the analysis, the results were the same.
Blastic features.Virtually all 80 cases had at least a few cells with larger nuclei, finer chromatin, and inconspicuous nucleoli; however, in the majority of cases, these cells were present in small numbers. When present in increased numbers, these lymphoblast-like cells were almost always accompanied by an increase in mitotic activity and, occasionally, the presence of tingible body macrophages (Fig 3B). These cases were designated as having prominent features of cytologic transformation. In a minority (n = 5), the blastic cells were so numerous that the histology was nearly indistinguishable from that of lymphoblastic lymphoma; these cases were designated blastic MCL (Fig 3C). The mean MS in the blastic MCL cases was 57.
The OS was significantly shorter for those cases with blastic morphology (Fig 3D). No statistically significant differences in survival were observed between the 16 cases that were transformed to some degree but not truly blastic and the remaining 59 cases that showed no evidence of transformation.
PB Findings
PB films were available for review in 69 cases. The results are summarized in Table 3. The typical PB appearance of circulating MCL was a polymorphous mixture of small, medium, and large lymphocytes, a pattern also described by others.17 The predominant cell type in most cases had a slightly irregular nucleus with fine chromatin, a small nucleolus, and a thin rim of gray-blue cytoplasm. Cells with a small cleaved or chronic lymphocytic leukemia (CLL)-like morphology were often present, as were immature cells with L1 and L2 lymphoblast-like morphology (Fig 5A). In 1 case, the blastic population predominated, creating the initial impression of acute lymphoblastic leukemia. Although absolute lymphocyte counts were not recorded, a significant proportion of cases with PB involvement did not have an elevated lymphocyte count by peripheral smear assessment. Leukemic involvement at diagnosis was defined as the presence of any detectable circulating MCL cells observed on the PB smear at the time of staging and was confirmed by flow cytometry in all cases in which the number of circulating MCL cells was low.
(A) PB involvement in MCL is characterized by a polymorphous cell population including larger cells with immature nuclei and prominent nucleoli. (B) OS of 80 cases of MCL based on PB involvement at diagnosis. Those cases positive for PB involvement (n = 27) were associated with a significantly shorter survival when compared with those in which PB was not involved or not assessed (n = 53).
(A) PB involvement in MCL is characterized by a polymorphous cell population including larger cells with immature nuclei and prominent nucleoli. (B) OS of 80 cases of MCL based on PB involvement at diagnosis. Those cases positive for PB involvement (n = 27) were associated with a significantly shorter survival when compared with those in which PB was not involved or not assessed (n = 53).
OS was compared between those patients that presented with PB involvement and the remainder of the patients in which PB involvement was either not present or unknown. Survival was significantly shorter in those who were leukemic at presentation (Fig 5B).
BM Biopsy Findings
Staging BM trephine biopsies were performed in 75 patients. In 47, there was clear histological evidence of involvement by MCL, the patterns of which are summarized in Table 4. In 3 cases, the core biopsy specimen was histologically nondiagnostic; however, in each of these 3, flow cytometric immunophenotyping showed a clonal B-cell population with CD5 coexpression. In 2 cases, the core biopsy specimen was suspicious but not diagnostic for involvement by MCL, and, in 23, no evidence of MCL was observed. Biopsies were not performed in 5 cases for various reasons including advanced comorbid neurological disease (n = 2), the presence of circulating lymphoma cells (n = 1), and undefined (n = 2).
In all histologically positive BM biopsy specimens, the lymphomatous infiltration was found predominantly in an interstitial or intertrabecular location, arranged in either nodular aggregates or diffuse infiltrates, or a combination of both. A few cases showed a prominent paratrabecular pattern reminiscent of small cleaved-cell lymphoma. In all cases, the cellular morphology was virtually identical to that of MCL observed in lymph nodes, lacking large transformed cells and proliferation centers. In 1 case, the cytomorphology was indistinguishable from acute lymphoblastic leukemia. Prognostic significance was determined by comparing those cases (n = 50) that were positive for involvement with the remainder of cases (n = 30), in which BM involvement was not evident (n = 25) or was unknown (n = 5). No significant difference in survival was found (data not shown). Outcome was also assessed based on the degree of staging BM involvement, estimated on the core biopsy specimen as less than or greater than 50% (Table 4). Those with heavy involvement by MCL (n = 12) tended to have a shorter OS than did those with partial involvement (n = 35), although the results were of borderline significance (median OS, 26 v 45 months; P = .06; data not shown).
Sequential Biopsies: Histological Patterns of Disease Progression
Thirty-seven patients underwent additional biopsies during the course of their illness. The material examined included BM (n = 9), extranodal tissue (n = 9), lymph node (n = 5), spleen (n = 4), fine-needle aspirate of an involved site (n = 7), and PB (n = 3). A median period of 22 months (range, 1 to 70 months) separated the procurement of these specimens from the time of the diagnostic biopsy. In 29 of these cases (78%), the cytology and/or architecture were unchanged from the time of diagnosis (median interval from original biopsy, 15 months; range, 1 to 67 months). In the remaining 8 (22%), increased numbers of larger, lymphoblast-like cells were observed, indicating cytologic transformation (median interval from original biopsy, 34 months; range, 14 to 70 months). Of these 8, the 5 open lymph node biopsy specimens showed more mitotic activity and blastic cells than were observed in the original biopsy specimens, but none were frankly blastic. In another 2 cases, increased numbers of blastic cells were present in the PB. In the eighth case, transformation was diagnosed on a lymph node fine-needle aspirate. Large noncleaved cells were not observed in any of this material. Nodal architecture remained diffuse in 4 cases, nodular in 1 case, and changed from nodular to diffuse in 1 case. All 8 patients in which cytologic change was found died within 12 months (median, 9 months), whereas only 16 of 29 patients without cytologic change have died (median follow-up period for all 29 patients, 8 months; range, 0 to 67 months). No significant difference in OS between the two groups was found.
Immunophenotypic Findings
Immunophenotyping by flow cytometry was performed in 49 cases (19 from lymph node tissue, 26 from BM or PB, and 4 from extranodal or unspecified sites). In 5 cases, the results were not diagnostic of lymphoma. Results of the 44 positive cases are shown in Table 5. The characteristic immunophenotype of the MCL cases analyzed was CD19+, CD20+, CD5+, and FMC-7+ and CD10− and CD23−, with a slight preponderance of λ surface Ig (SIg) positivity. SIg brightness was documented in only one quarter of the cases, and, in all of these, SIg was moderate to bright. Three cases showed an aberrant immunophenotype. One coexpressed both CD5 and CD10, and another lacked CD5 expression, while the third weakly coexpressed CD23. All 3 had other data to substantiate the diagnosis of MCL. CD11c expression, although not shown in Table 5, was consistently negative in all cases analyzed.
Cytogenetic Findings
Cytogenetic analysis was performed in 31 cases. Results are summarized in Table 6. The translocation t(11; 14) (q13; q32), characteristic of MCL, was the most frequently occurring abnormality in this group. The next most common groups of abnormalities involved chromosomes 9 and 17. Monosomy 9 was observed in 2 cases; whereas, in 3 cases, structural abnormalities of 9q were found, ie, an inversion, a deletion, and a balanced translocation with 14q32. In 2 cases, 17p11 was disrupted because of balanced translocations with chromosomes 3 and 15, respectively; whereas, in another 2 cases, monosomy 17 was found. The cases with abnormal clones not obviously including t(11; 14) may have had complex or cryptic alterations involving the bcl-1 and Ig heavy-chain loci. No significant differences were found between the 14 cases with t(11; 14) and the 4 cases in which analysis was successful but failed to show a t(11; 14). Similarly, no differences in survival could be shown between the groups of patients with chromosome 9 and 17 abnormalities and the remainder of MCL cases. However, the number of cases was too small to make a meaningful statistical comparison.
Molecular Genetic Findings
SA for bcl-1 gene rearrangement was performed in 20 cases. Table 7 summarizes these results and compares them with the cytogenetic results. No significant differences in survival could be shown between the 11 cases with and 9 cases without SA evidence of bcl-1 rearrangement.
DISCUSSION
The pathology of MCL is well defined, but the criteria for and clinical relevance of histological subclassification remain controversial. Some regard MCL with an MZ architecture as “low grade,” whereas others find that survival in these cases is similar to that of cases with a diffuse growth pattern.2 In addition, some studies have suggested that factors such as mitotic activity and increased numbers of blast-like cells signal a worse outcome. Resolution of these issues has been slow because of the small numbers of cases available for study and the lack of consensus diagnostic criteria. This analysis of 80 cases of MCL, the largest series to date, was undertaken with the intent to help resolve some of these questions.
Attempts at determining which pathological and clinical factors are of prognostic value in patients with MCL have produced variable results. In particular, several studies suggest that the MZ variant behaves in a more indolent manner than the diffuse type,5,25 with a quoted OS of 88 months,14 whereas others have shown no differences in survival.6 Others have shown decreased survival in cases with increased mitotic activity,8,11,14 prominent blastic morphology,4,5,6,14,26 or PB involvement.6,8,15,17 Other factors examined include age, sex, B symptoms, splenomegaly, remission status, hemoglobin level, platelet count, lymphocyte count, serum albumin, serum sodium, CD10 positivity, Ki67 positivity, cyclin D1 expression, and p53 gene anomalies with varying results.6,10,11,14 25-27
In this study, all 80 cases had clinical features and survival characteristics fully compatible with those described for MCL, as summarized in Table 1 and shown in Fig 1. Of the IPI clinical prognostic variables,24 prognosis was significantly influenced by PS but was not significantly influenced by age, stage, LDH level, and extranodal involvement, although a trend toward a worse outcome was observed for the latter four factors. The IPI score also did not significantly predict for patient outcome. Although the numbers of patients, particularly those with limited-stage disease, may not have been large enough to permit detection of a survival difference using the IPI prognostic variables, it is more likely that simply having the diagnosis of MCL, with its inherently poor outcome, supersedes any prediction of behavior based on clinical factors. Definitive statements of effectiveness of certain treatment protocols were not possible in this study because no treatment group did well. Even the more intense BP-VACOP/IRRT regimen did not produce a survival advantage despite being administered only to patients under the age of 60.
All 80 cases met the accepted histological criteria for MCL.1 Particularly useful features distinguishing MCL from other diffuse small-cell ML include the monotonous lymphoid infiltrate, absence of growth centers, scattered epithelioid histiocytes, perivascular hyaline sclerosis, and virtual absence of large transformed cells. Although mitotic figures were conspicuous in most cases, it is important to note that, in 22 cases, the MS was low (≤5). Also, it is apparent from examination of sequential biopsy specimens that the pattern of transformation of MCL can be best described as a progressive increase in cells with slightly larger nuclei and finer chromatin, but a lack of nucleoli in tissue sections. This cytologic transformation is often accompanied by an increase in mitotic rate.
The prognostic significance of three histological features, architecture, mitotic activity, and relative number of lymphoblast-like cells is summarized above; however, several points need to be addressed. First, this study failed to show any significant differences in OS between the MZ, nodular, and diffuse subtypes. These results are similar to the findings of Norton et al6 but contrast those of Duggan et al,14 who found MCL with an MZ architecture to be indolent. Although the appearance of an MZ pattern is well described in the literature, the criteria for a true MZ pattern are undefined and are subject to interobserver variability. When compared with other MCL series, the proportion of MZ cases observed here (6%) is similar to that observed by Norton et al6 (6%) and Pittaluga et al15 (11%) but is significantly lower than that reported by Lardelli et al5 (55%) and Weisenburger et al25 (30%), two studies in which there were demonstrable differences in survival between MZ and other architectural subtypes. The reasons for this are unclear but are likely to be caused by differences in criteria for defining an MZ pattern, rather than true geographic differences in frequency. Because the criteria for defining an MZ pattern in this study may have been more strict than those in other series, we also pooled the nodular and MZ cases together and compared them with the diffuse cases. However, once again, no difference in OS was found.
A diagnosis of blastic MCL, defined in this study and by others5 as MCL with the appearance of lymphoblastic lymphoma, assigns the patient a very unfavorable prognosis. This histological pattern should be relatively reproducible; however, it is unclear what number of blastic cells is needed to make the diagnosis. The fact that others refer to similar cases as “blastoid,”6 “large-cell,”26 or “anaplastic”27 variants attests to the current lack of standardized diagnostic criteria. Attempts have been made by others to count large cells manually14,28 or by image analysis26; however, the cytomorphology of MCL cell is a spectrum, making it a difficult task when applied in a routine clinical setting, excepting those cases with florid blastic change as described herein. More objective methods of assessing the proliferation rate, including mitotic counts and Ki67 nuclear antigenic expression, have also been applied to MCL and appear to be closely linked with blastic morphology, as would be expected. It has been shown by the results of this study and by those of others, that increased mitotic activity predicts for a worse outcome, although the exact number of mitoses at which prognosis was found to be different varies from study to study (10 of 10 hpf,14 20 of 30 hpf,8 and 20 of 10 hpf11 ). Although not evident from examination of the results of these studies, this variability may be the result of differences in patient populations, but is more likely to be caused by the inherent interobserver variability of counting mitotic figures. Regardless, the data indicate that prognosis is closely linked to the mitotic count in MCL, which is similar to that observed in other lymphomas of aggressive histology,29 and mitotic activity and blastic morphology are unlikely to be independent variables, although this postulate can only be tested with multivariate analysis.
Cytologic evidence of blastic change in sequential biopsy specimens was found in 8 patients (11% of the total nonblastic cases), all 8 of whom died within 12 months. However, the OS of these patients was no different from those without transformation and may reflect a lead-time bias: the patients with transformation were serially biopsied later in their course (median, 34 months from original biopsy) than were those without transformation (median, 15 months). Unfortunately, the exact incidence of blastic change in this patient population is not known because autopsy follow-up results were unavailable, but the results of Norton et al6 suggest that it occurs at a higher frequency (28%) than is currently recognized.
The high incidence of PB and BM involvement by MCL at diagnosis observed in 34% and 63% of cases, respectively, is in keeping with that found by others.6,11 15 PB involvement at diagnosis predicted for a shortened survival in our study; however, interestingly, the presence or absence of BM involvement did not. Although heavy BM infiltration was associated with a trend toward shorter survival, no correlation of this feature with PB involvement could be shown. The predictive power of PB involvement may be the result of a bias toward increased numbers of cases with MS of greater than 20 in the leukemic group versus that in the nonleukemic group (41% v 17%; P = .03); in contrast, cases with MS of greater than 20 were evenly distributed throughout both positive and negative BM cases (data not shown). Multivariate analysis would be necessary to confirm PB involvement as an independent variable; however, these data imply that, in some cases, leukemic involvement may reflect increased biological aggressiveness rather than only overall tumor burden.
Immunophenotypically, the 44 cases with diagnostic analyses had, with 3 exceptions, the typical immunoprofile of MCL. Antibody FMC-7, described by others in the differentiation of subgroups of B-cell lymphoproliferative disorders,30 when used in combination with CD23, was very useful in distinguishing MCL from CLL/small lymphocytic lymphoma (SLL) in our series, because the majority of cases of MCL were FMC-7+ and CD23−, whereas the opposite pattern occurs in the majority of CLL/SLL cases.17 31
No morphologic or clinical differences could be attributed to the presence or absence of the t(11; 14)(q13; q32) or bcl-1 gene rearrangement. Addtionally, no outcome or histological differences were observed for those cases with chromosome 9 or 17 abnormalities, but the number of affected cases was too small to allow for a meaningful statistical comparison. Most reports have identified t(11; 14) and bcl-1 gene rearrangements as highly specific for MCL32-34; however, these abnormalities have also been rarely described in SLL and plasma cell dyscrasias. In a recent report in which the presence of a t(11; 14) or bcl-1 rearrangement was associated with ML with morphologic findings atypical for MCL, the clinical course of these patients was similar to that of MCL.35 Similarly, we have recently observed a case of ML with a t(11; 14) and a bcl-1 rearrangement that had classical proliferation centers in which the clinical course was more akin to MCL than to SLL. We were unable to show a survival difference in this study for cases with or without a t(11; 14) or a bcl-1 rearrangement. It is unlikely that the presence of these cytogenetic and/or molecular genetic findings will be prognostically important, because the recent development of sophisticated fluorescence in situ hybridization techniques has shown that virtually all cases of MCL possess these abnormalities.36,37 We did not stain these cases for cyclin D1 protein, but virtually all cases of MCL overexpress this protein,3 38-42 making it a useful diagnostic reagent but an unlikely prognostic marker. Perhaps, the interaction of cyclin D1 with other cellular proteins (retinoblastoma gene, p16, p21, ubiquitin, and so on) contributes to lymphoma development, and measurement of one or more of these proteins may prove to be independent prognostic factors in MCL.
In summary, this study confirms the aggressive nature of MCL and provides evidence that MS, blastic morphology, and leukemic involvement at diagnosis predict for poor outcome. Standard clinical indicators of prognosis such as age, stage, number of extranodal sites, or presence of B symptoms had little discernable impact because the overall prognosis was so poor. Such factors are unlikely to be predictive until more effective treatments become available. We have also shown that, although architecture does not have prognostic importance, there is a need to develop standardized histological criteria for both “MZ” and “blastic” morphologies. Resolution of these problems together with large collaborative studies are crucial to provide further insight into the effective treatment and possible cure of this disease.
ACKNOWLEDGMENT
The authors thank Drs S. O'Reilly, P. Hoskins, and T. Shenkier for their help in providing clinical data for this study; Drs C. Coppin and A. Coldman for their assistance with statistical analysis; and Ms C. Wong for her help with data collection.
Address reprint requests to Randy D. Gascoyne, MD, Department of Pathology, British Columbia Cancer Agency, 600 W 10th Ave, Vancouver, British Columbia, V5Z 4E6, Canada.